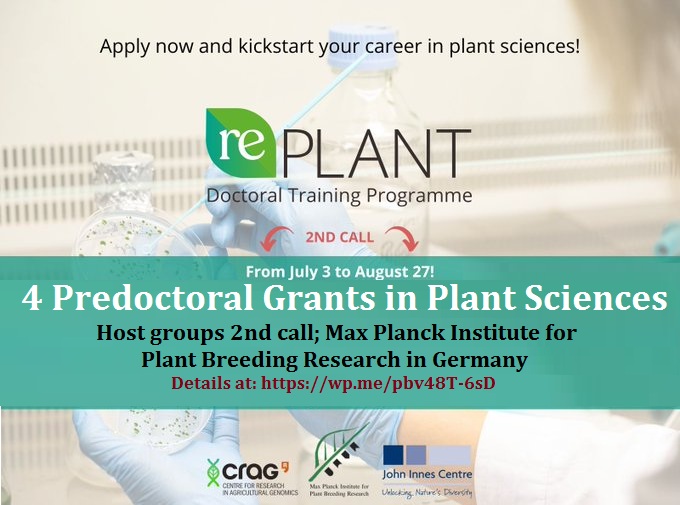
📌 4 Predoctoral (PhD) Grants in Plant Sciences at Max Planck Institute for Plant Breeding Research🌱🧬 in Cologne, Germany 🇩🇪... Please Retweet and spread the word! For details visit: wp.me/pbv48T-6sD

Alba Myers❤️🥬🌽🌱💫🇺🇸🌎
@albamyers83968
UF-EREC Biological Scientist II/Laboratory Manager with demonstrated history on producing in vitro protocols on ornamentals and working on the farming industry.
ID: 1671991680302563333
22-06-2023 21:21:17
34 Tweet
23 Takipçi
33 Takip Edilen



Great week for #lettuce research … Byron Manzanero is a #PhD and Hannah Mather a Ms Sc …. Both did a great job in their seminars.Thanks to their committee member, and Kevin Begcy for collab… training the #plantbreeders of the future UF IFAS Everglades REC - Belle Glade UF/IFAS-PlantBreeding Hort. Sciences at UF




Enjoyed the first 2-day session of LEAD IFAS! UF IFAS Everglades REC - Belle Glade UF/IFAS Agronomy at UF




Monthly biomass sampling in DOE funded bioenergy project to estimate seasonal biomass accumulation and nutrient uptake in energycane and sugarcane! UF IFAS Everglades REC - Belle Glade UF/IFAS Agronomy at UF Argonne National Lab